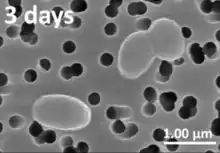

Vibrio harveyi
| Vibrio harveyi | |
|---|---|
| |
| Scientific classification | |
| Domain: | Bacteria |
| Phylum: | Pseudomonadota |
| Class: | Gammaproteobacteria |
| Order: | Vibrionales |
| Family: | Vibrionaceae |
| Genus: | Vibrio |
| Species: | V. harveyi |
| Binomial name | |
| Vibrio harveyi Johnson and Shunk 1936 Baumann et al. 1981 | |
| Synonyms | |
|
Beneckea harveyi (Johnson and Shunk 1936) Reichelt and Baumann 1973 | |
Vibrio harveyi is a Gram-negative, bioluminescent, marine bacterium in the genus Vibrio. V. harveyi is rod-shaped, motile (via polar flagella), facultatively anaerobic, halophilic, and competent for both fermentative and respiratory metabolism. It does not grow below 4 °C ( optimum growth: 30° to 35 °C). V. harveyi can be found free-swimming in tropical marine waters, commensally in the gut microflora of marine animals, and as both a primary and opportunistic pathogen of marine animals, including Gorgonian corals, oysters, prawns, lobsters, the common snook, barramundi, turbot, milkfish, and seahorses.[1] It is responsible for luminous vibriosis, a disease that affects commercially farmed penaeid prawns.[2] Additionally, based on samples taken by ocean-going ships, V. harveyi is thought to be the cause of the milky seas effect, in which, during the night, a uniform blue glow is emitted from the seawater. Some glows can cover nearly 6,000 sq mi (16,000 km2).
Quorum sensing
Groups of V. harveyi bacteria communicate by quorum sensing to coordinate the production of bioluminescence and virulence factors. Quorum sensing was first studied in V. fischeri (now Aliivibrio fischeri), a marine bacterium that uses a synthase (LuxI) to produce a species-specific autoinducer (AI) that binds a cognate receptor (LuxR) that regulates changes in expression. Coined "LuxI/R" quorum sensing, these systems have been identified in many other species of Gram-negative bacteria.[3] Despite its relatedness to A. fischeri, V. harveyi lacks a LuxI/R quorum-sensing system, and instead employs a hybrid quorum-sensing circuit, detecting its AI through a membrane-bound histidine kinase and using a phosphorelay to convert information about the population size to changes in gene expression.[4] Since their identification in V. harveyi, such hybrid systems have been identified in many other bacterial species. Qrr RNA molecules are responsible for controlling regulator translation, repressing and promoting factors dependent on cell density. V. harveyi uses a second AI, termed autoinducer-2 or AI-2, which is unusual because it is made and detected by a variety of different bacteria, both Gram-negative and Gram-positive.[5][6][7] Thus, V. harveyi has been instrumental to the understanding and appreciation of interspecies bacterial communication.
References
- ↑ Owens, Leigh; Busico-Salcedo, Nancy (2006). "Vibrio harveyi: Pretty Problems in Paradise (Chapter 19)". In Thompson, Fabiano; Austin, Brian; Swings, Jean (eds.). The Biology of Vibrios. ASM Press.
- ↑ Austin B, Zhang XH (2006). "Vibrio harveyi: a significant pathogen of marine vertebrates and invertebrates". Letters in Applied Microbiology. 43 (2): 119–214. doi:10.1111/j.1472-765X.2006.01989.x. PMID 16869892.
- ↑ Waters CM, Bassler BL (2005). "Quorum Sensing: Cell-to-Cell Communication in Bacteria". Annual Review of Cell and Developmental Biology. 21: 319–346. doi:10.1146/annurev.cellbio.21.012704.131001. PMID 16212498. S2CID 16560276.
- ↑ Bassler BL, Wright M, Showalter RE, Silverman MR (1993). "Intercellular signalling in Vibrio harveyi: sequence and function of genes regulating expression of luminescence". Molecular Microbiology. 9 (4): 773–786. doi:10.1111/j.1365-2958.1993.tb01737.x. PMID 8231809. S2CID 36357210.
- ↑ Surette MG, Miller MB, Bassler BL (1999). "Quorum sensing in Escherichia coli, Salmonella typhimurium, and Vibrio harveyi: a new family of genes responsible for autoinducer production". Proceedings of the National Academy of Sciences. 96 (4): 1639–44. doi:10.1073/pnas.96.4.1639. PMC 15544. PMID 9990077.
- ↑ Schauder S, Shokat K, Surette MG, Bassler BL (2001). "The LuxS family of bacterial autoinducers: biosynthesis of a novel quorum-sensing signal molecule". Molecular Microbiology. 41 (2): 463–476. doi:10.1046/j.1365-2958.2001.02532.x. PMID 11489131.
- ↑ Chen X, Schauder S, Potier N, Van Dorsselaer A, Pelczer I, Bassler BL, Hughson FM (2002). "Structural identification of a bacterial quorum-sensing signal containing boron". Nature. 415 (6871): 545–549. doi:10.1038/415545a. PMID 11823863. S2CID 4334017.